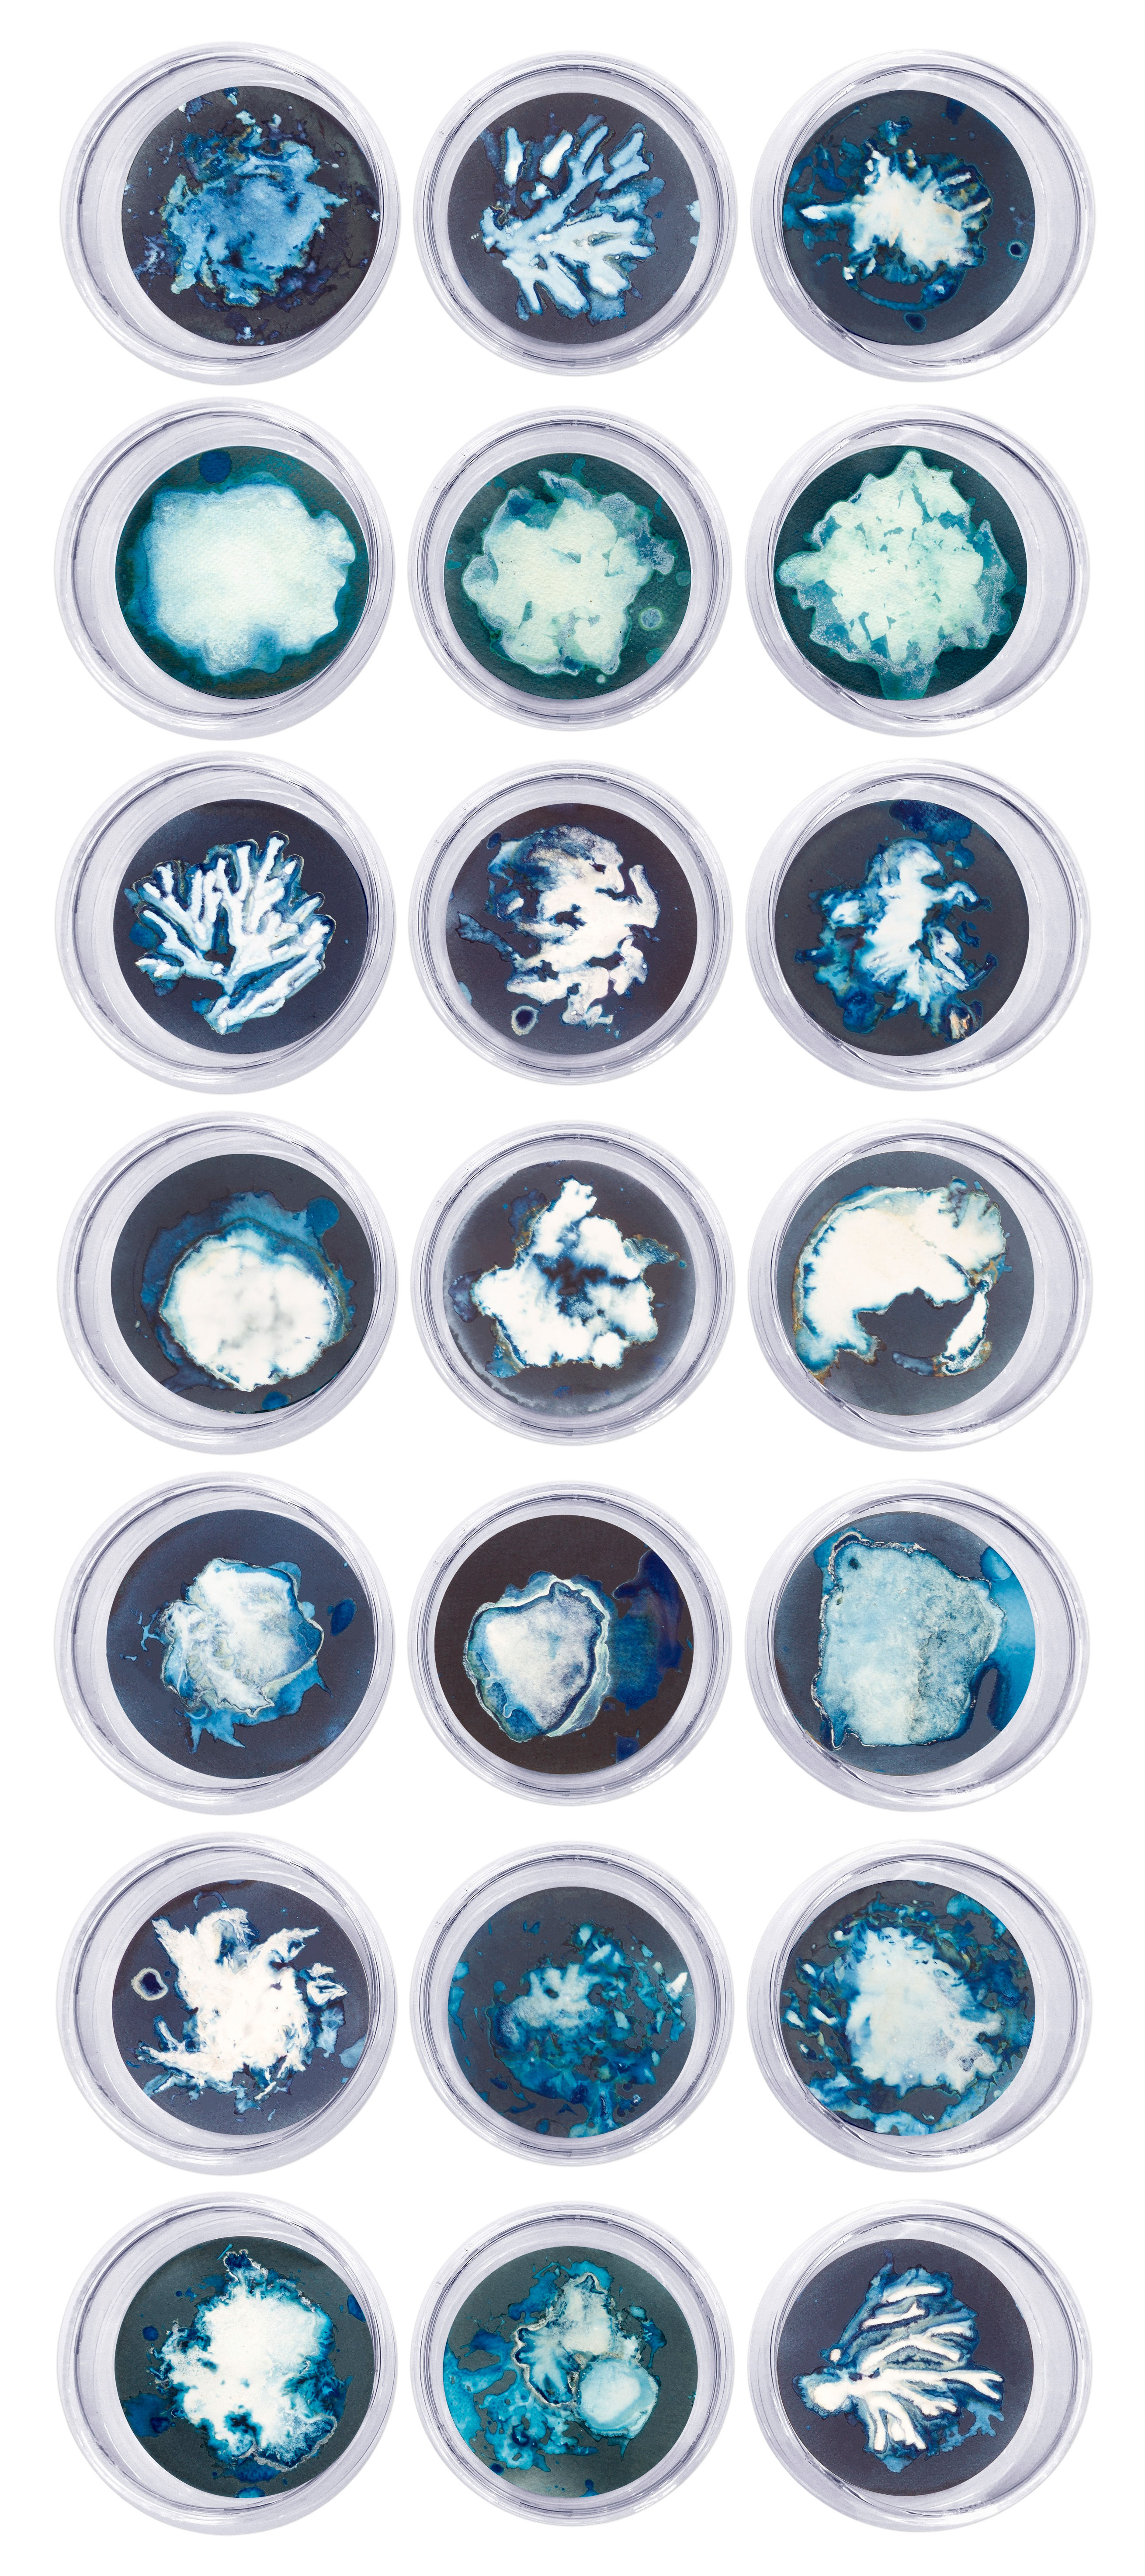
Paola Dávila_ still life photography_sea_nature_conceptual art_conceptual photography_

riginally presented as Set of 21 Photographs, this body of work expands marine organic abstraction photography into sculptural register—mounted in borosilicate glass petri dishes that frame each piece as specimen and artwork simultaneously. Algae, organic remnants, and aquatic residues inhabit the surface not as depiction but as presence: water as agent rather than subject. Through direct contact with photosensitive material, Dávila allows marine matter to inscribe itself onto the image plane, transforming still life into ecological dramaturgy. The deep blue tones suspend the viewer between oceanic fragility and persistence, where maritime life becomes both imprint and event.
Water is constant in the artist's visual investigation, for her water is no longer the stage in which the body's memory bursts, but rather the environment and protagonist, constant operator of the image, water reveals, unveils, performs. The landscape is recorded by direct contact with the paper and the sensitive emulsion, and in this case, organic matter and the vestige of living organisms inhabit it. That is, there is no representation, but rather its direct presence as part of the work. It is almost dramaturgy, a high-sounding discussion with the visual arts, the history of Landscaping is overturned.
Acquire this marine organic abstraction photography where ocean matter directly inhabits photosensitive surface—algae as presence, water as author. From Mareas Algas by Paola Dávila. Available at The Art Design Project, Miami Beach.
Set of 21 Marine Organic Abstraction Photography. Mareas Algas by Paola Dávila
Set of 21 Photograhs, 2022
From the series Mareas
Cyanotype on 300 gr cotton paper
Mounted in a high-resistance borosilicate glass petri dish
Dimensions:
Overall size: 84 cm H x 36 cm W x 2.4 cm Deep.
Individual Image size: 10.5 cm D.
Each Petri dish: 12 cm Dm. x 2.4 cm Deep.
1. Algas 14, 41 y 68.
2. Sal 22, 23 y 24.
3. Algas 11, 22 y 67.
4. Esponjas 8, 11 y 16.
5. Medusas 11, 12 y 13.
6. Algas 23, 63 y 64
7. Algas 75, 83 Y 26.
Unique
Signed by the artist
Framed
Paola Dávila was born in Oaxaca, Mexico, in 1980. She studied Visual Arts at the National School of Plastic Arts of Mexico, where she attended the contemporary painting seminar. He also attended theory and photography workshops. In 2002, he received the National Photography Prize at the Yucatan Visual Arts Biennial, the Acquisition Prize at the IV Libertad de Arte Contest, and the state scholarship for Jovenes Creadores FOECA from the state of Oaxaca. It has nine individual exhibitions and more than 30 collective exhibitions both in Mexico and abroad. During 2010 he received the Tierney Grant awarded by the Tierney Foundation of New York for the Manuel Álvarez Bravo Photographic Center to carry out the Temporary Interiors project. He has been a beneficiary of the Young Creators Program, FONCA, in 2003, 2006 and 2011. In 2014 he received the Scholarship for Artistic Exchanges and Residencies, FONCA-Land Salzburg of Austria, thanks to which he started the Schrebergarten project. In 2017 the City of Oaxaca awarded her the degree of Distinguished Citizen, in recognition of her artistic career. In 2019 he obtained the title of Master of Visual Arts from UNAM with honorable mention. In 2021 he won the acquisition prize at the XIX National Photography Biennial, organized by the Image Center. Since 2020 he is a member of the National System of Art Creators, FONCA, CONACULTA.